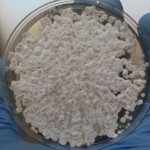
fungus of white nose

Biowarfare saves bats from killer fungus
Briefly exposing animals to gases spewed by certain bacteria appears to cure infection
The face of success. This little brown bat was successfully treated for white nose syndrome and then released into the wild in May 2015.
U.S Forest Service
Share this:
- Share via email (Opens in new window) Email
- Share on Facebook (Opens in new window) Facebook
- Share on X (Opens in new window) X
- Share on Pinterest (Opens in new window) Pinterest
- Share on Reddit (Opens in new window) Reddit
- Share to Google Classroom (Opens in new window) Google Classroom
- Print (Opens in new window) Print
Researchers looking to cure white-nose syndrome — a major killer of American bats — have just reported a big success. A new treatment has saved the lives of infected bats. And it offers a ray of hope for their wild kin. The fungus responsible for white-nose syndrome has already threatened some of their populations with extinction.
The effectiveness of the potential cure could be seen on May 19. As darkness approached, scientists gathered near caves in Hannibal, Mo. That night, they released 150 treated bats back into the wild. Last fall, those same bats had been suffering from white-nose syndrome.
Over the past decade, this infection has claimed the lives of more than 5.7 million bats in the United States and Canada. But on that Tuesday, researchers declared the treated animals healthy enough to return to the caves they call home. In short order, each flew off into the dusky night sky.
Scientists have explored many treatments for white-nose syndrome, but that evening marked the first time treated bats had been returned to the wild. Biologist Craig Willis, who studies bats at the University of Winnipeg in Canada, says he’s encouraged by the success. At the same time, “there’s still a lot we need to know [about bats and the treatment] before we can get close to calling this or anything else a ‘cure,’” says Willis, who was not involved in the project.

Conservation biologist Sybill Amelon works for the U.S. Forest Service in Columbia, Mo. She played a major role in developing the new treatment. The therapy relies on a bacterium called Rhodococcus rhodochrous (ro-doh-KOK-kus ROH-doh-krus). While Amelon is excited about the treatment’s early success, she cautions that the recent trial involved only a small number of bats. What’s more, she notes, the treatment only cured about half of the infected animals.
She and her team have kept some of the recovered bats and plan to watch them over the next winter to make sure they stay healthy. It’s too early to know how lasting the new treatment will prove.
Still, saving half of a group of infected bats is a major milestone: They can return to their caves to rebuild populations that had been dying off. The new therapy will likely be just one of many tools that biologists turn to as they work to curb the deadly impacts of white-nose syndrome.
Learning from bananas
Inspiration can come from unlikely places. Christopher Cornelison is a biologist at Georgia State University in Atlanta. He always had a passion for wildlife. He first heard about the fungal disease wiping out American bats by the thousands, when he was a graduate student. He had been part of a team working with R. rhodochrous. These researchers had been studying how these bacteria can break down chemicals in the soil.
But scientists on the team noticed the bacterium had an unusual trait. It kept bananas from turning moldy. And the bacteria didn’t even have to touch the bananas or the mold. Gases released into the air by the bacteria shut down growth of the mold, which is a type of fungus. Bananas stored in spaces without these bacteria did grow mold.
Suddenly a light bulb went off, Cornelison recalls. “Perhaps if the bacterium can keep mold from growing on bananas, it can prevent mold from growing on a bat.”
Further testing would confirm he was right. In 2012, a Forest Service colleague of Amelson sent some of Cornelison’s data to her in Missouri. And with that, a collaboration was born. In addition to Cornelison and Amelon, their team now includes Daniel Lindner. He’s a Forest Service mycologist, or fungi expert, in Madison, Wisc.
“I’m fascinated with fungi and mushrooms and all the things they can do,” says Lindner. “At the same time, when they’re out of place they can cause devastating diseases.” Like white-nose syndrome.
From lab to field
For two years, Amelon, Cornelison and Lindner were part of a team that ran laboratory tests to fine-tune the bacterial treatment. Last fall, at two sites in Missouri and two in Kentucky, the scientists went to caves where bats had begun hibernating for the winter. There they collected infected animals. They placed each bat inside a cooler large enough to hold about 100 cans of soda. This cooler also held a small lab dish in which the bacterium was growing. After 24 to 48 hours, the scientists removed each bat and placed it in a protected, fenced pen that they had created in its home cave. (The fence helped keep predators out.)
This spring, the scientists returned. About half of the infected bats no longer showed any sign of infection. These survivors are the bats that were recently set free. (The scientists haven’t yet published their results in a scientific journal, so they won’t report exact numbers of how many bats were treated, and how many survived.)
As promising as the trial appears, there are still plenty of questions that will need to be answered before the therapy can be used in caves and other hibernacula — sites where bats hibernate over winter months.
One big concern is over everything else that lives at these sites. Hibernacula host a dizzying variety of microbes, fungi, animals and other organisms. All live together in a delicate balance. Adding R. rhodochrous could upset that balance.
For instance, notes Kenneth Field, “There are thousands of other species of fungi that live in caves that may or may not be affected by the bacterium.” This biologist at Bucknell University in Lewisburg, Pa., was not involved in the study. A concern, he told Science News for Students, is that adding some new bacterium to the mix might imperil the whole ecosystem.

Even if the bacterium proves safe, treating hibernating bats will present some challenges. Making enough bacteria to treat an entire hibernaculum could require a lot of work — and money. So researchers will have to find a low-cost way to rear the bacteria.
Still, watching that initial wave of recovered bats fly into Hannibal’s night sky was a first step — and a remarkably promising one.
Power Words (for more about Power Words, click here)
bacterium (plural: bacteria) A single-celled organism. These dwell nearly everywhere on Earth, from the bottom of the sea to inside animals.
bat A type of winged mammal comprising more than 1,100 separate species — or one in every four known species of mammal.
compound (often used as a synonym for chemical) A compound is a substance formed from two or more chemical elements united in fixed proportions. For example, water is a compound made of two hydrogen atoms bonded to one oxygen atom. Its chemical symbol is H2O.
conservation The act of preserving or protecting something. The focus of this work can range from art objects to endangered species and other aspects of the natural environment.
conservation biologist A scientist who investigates strategies for helping preserve ecosystems and especially species that are in danger of extinction.
ecosystem A group of interacting living organisms — including microorganisms, plants and animals — and their physical environment within a particular climate. Examples include tropical reefs, rainforests, alpine meadows and polar tundra.
extinction The permanent loss of a species, family or larger group of organisms.
field A term to describe a real-world environment in which some research is conducted, such as at sea, in a forest, on a mountaintop or on a city street. It is the opposite of an artificial setting, such as a research laboratory.
flu (short for influenza) A highly contagious viral infection of the respiratory passages causing fever and severe aching. It often occurs as an epidemic.
fungus (plural: fungi) One of a group of single- or multiple-celled organisms that reproduce via spores and feed on living or decaying organic matter. Examples include mold, yeasts and mushrooms.
hibernaculum (pl. hibernacula) A sheltered space where animals hibernate.
infection A disease that can spread from one organism to another.
microbe Short for microorganism.A living thing that is too small to see with the unaided eye, including bacteria, some fungi and many other organisms such as amoebas. Most consist of a single cell.
mortality Death — from mortal, meaning deadly.
mycology The field of biology that specializes on fungi (including mushrooms and molds). Scientists who work in this field are sometimes called mycologists.
population A group of individuals from the same species that lives in the same area.
white-nose syndrome A fungal disease affecting bats. The fungus, Pseudogymnoascus destructans, lives in caves where bats hibernate through the winter. It causes a white dusting on their noses and on other areas of the body. The fungus causes dehydration and can eat holes through bats’ wings and blood vessels. Eventually, it weakens them, leaving them unable to fly and find food.